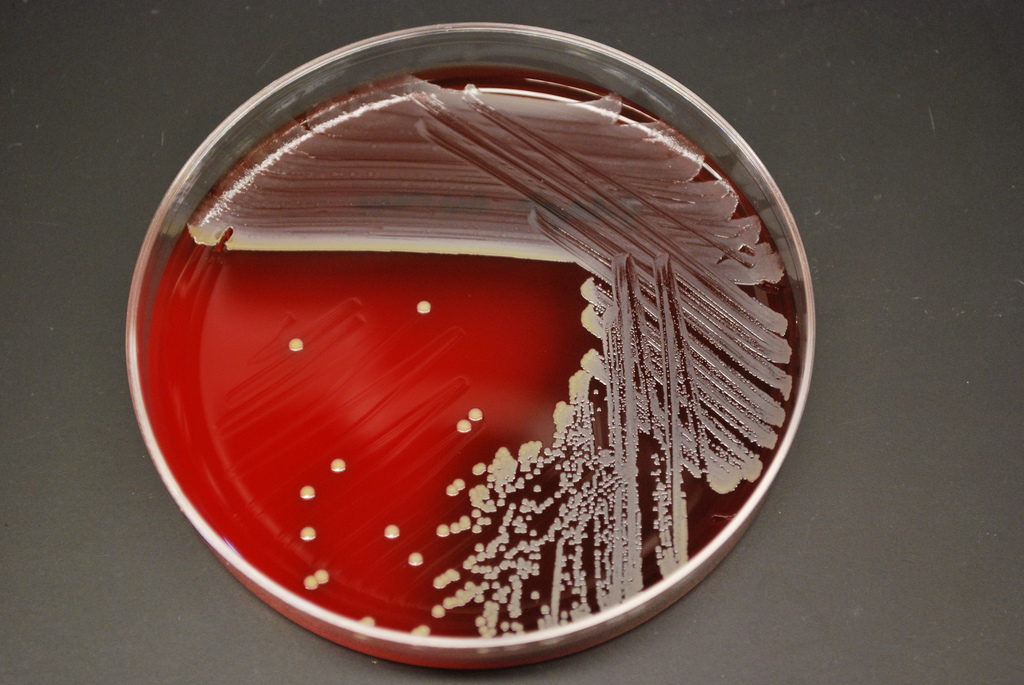

Il JRC (Joint Research Centre – UE) ha sviluppato e rilasciato il primo kit di riferimento certificato per valutare la presenza di enterotossina A nel formaggio. La sostanza è rilevabile in quantità comprese tra i subnanogrammi e i grammi. Per gli stafilococchi coagulasi, il tutto è stato possibile grazie alla collaborazione con il laboratorio EURL (European Union Reference laboratory) che è situato in Francia presso l’ANSES (Agency for Food, Environmental and Occupational Health and Safety). L’enterotossina stafilococcica provoca frequentemente malattie trasmissibili con gli alimenti.
I prodotti più interessati sono formaggi, uova, carni, ortaggi trattati (dalla lavorazione alla distribuzione) senza considerare le corrette norme igieniche.
Il reg. 1441/2007/CE definisce i canoni microbiologici adottabili agli alimenti e i procedimenti per ricercare la tossina nel latte e nei prodotti lattiero-caseari. Si utilizza uno dei test consentiti basandosi sulla estrazione, la concentrazione e l’identificazione immunochimica.
Gli esiti del test sono espressi in termini qualitativi (presenza/assenza).

IRMM-359 A-C è il kit di riferimento ed è composto da un bianco e da due positivi contenenti la tossina. Essendo stato creato secondo la ISO Guide 34 può essere usato da laboratori certificati ISO/IEC 17025 per verificare la validità dei propri metodi: controllo delle prestazioni e maggiore affidabilità delle misure.



Daniele Toni